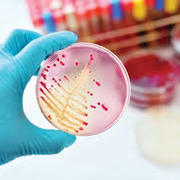

Learn Mikrobiology
Study Mikrobiology using smart web & mobile flashcards created by top students, teachers, and professors. Prep for a quiz or learn for fun!
Brainscape Certified flashcards
(0)
Decks
Flashcards
Learners
User Generated flashcards
(30)
Decks
Flashcards
Learners
-
Mikrobiologi
Mikrobiologi
By: Rr Isnaisa Salma Nazlaliyah
Mikrobiologi Kesehatan, Mikrobiologi Lingkungan, Mikrobiologi Pangan...4Decks132Flashcards1Learner -
Mikrobiologi
Mikrobiologi
By: R L
Virologi, Bakteriologi + generelt, Mykologi...4Decks62Flashcards1Learner -
Mikrobiologi
Mikrobiologi
By: Leia Lindberg
Smittämnen1Decks23Flashcards1Learner -
Mikrobiologi

Mikrobiologi
By: Lea A Åkerlund
Bakterier, Normalflora, Virus3Decks24Flashcards2Learners -
mikrobiologi
mikrobiologi
By: Benjamin Elkjær
Svampe, Orme, Virus...9Decks177Flashcards5Learners -
5.1 Medicinsk mikrobiologi og videregående immunologi
5.1 Medicinsk mikrobiologi og videregående immunologi
By: Martin Nguyen
Klinisk øvelse, Introduktion til mikrobiologi, Bakteriel struktur, vækst og metabolisme...58Decks601Flashcards4Learners -
Mikrobiologi
Mikrobiologi
By: Siv Anita
Den prokaryote cellen, Bakteriologi - sporer, Mere om bakteriecellens oppbygning...9Decks124Flashcards4Learners -
mikrobiologi
mikrobiologi
By: Roberta Dinsey kubi
mikrobio, mikro advanced, yStaphylococcus aureus...8Decks166Flashcards1Learner -
Mikrobiologi - bakteriologi
Mikrobiologi - bakteriologi
By: Annika Nørspang
Bakteriologi1Decks27Flashcards23Learners -
mikrobiologi

mikrobiologi
By: Lina Björnfot
bakteriesorter, mitos och cellcykel, DNA och RNA...7Decks129Flashcards2Learners -
Mikrobiologi 1
Mikrobiologi 1
By: Annie Lindström
FL1 - Energi, Enzymer och makromolekyler, Instuderingsfrågor Mikroskopi, Cellstruktur och organisation 1 + membran...9Decks165Flashcards1Learner -
mikrobiologi
mikrobiologi
By: Che Guevara
4.1 Parasit dr amalia, Mikrobiologi2Decks36Flashcards2Learners -
Mikrobiologi
Mikrobiologi
By: Emilie Olsen
Mikrobiologi - Blandet1Decks51Flashcards2Learners -
Mikrobiologi og humanfysiologi
Mikrobiologi og humanfysiologi
By: Malene Danielsen
Mikrobiologi, Humanfysiologi2Decks501Flashcards18Learners -
Oral Mikrobiologi
Oral Mikrobiologi
By: Fredrik A-U
Bakterier, Virus, Oral mikrobiologi självtest...6Decks107Flashcards2Learners -
Mikrobiologi
Mikrobiologi
By: Magnus Tornerefelt
Parasitologi1Decks59Flashcards1Learner -
Saliv Och Mikrobiologi
Saliv Och Mikrobiologi
By: Gustav Vallgren
Saliv, Immunologi, Allmän Mikrobiologi...6Decks140Flashcards10Learners -
Mikrobiologi
Mikrobiologi
By: Elsa Le Meur
Mykologi, Virologi, Mikrobiologi föreläsning 1...6Decks69Flashcards1Learner -
Klinisk mikrobiologi
Klinisk mikrobiologi
By: Anton Johansson
Virus, Normalflora, Klinisk mikrobiologi ORD...4Decks69Flashcards1Learner -
Mikrobiologi
Mikrobiologi
By: Louise Holm
Gram-positive, Gram-negative, Virus...6Decks79Flashcards5Learners -
Mikrobiologi

Mikrobiologi
By: Clara E
Antibiotika, Bakterietillväxt Faser, Probiotika...6Decks23Flashcards3Learners -
mikrobiologi
mikrobiologi
By: Sophia Valen Gundersen
bakterier, Diagnostisering + AB2Decks35Flashcards1Learner -
Mikrobiologi

Mikrobiologi
By: Sille Bertelsen
Immunforsvar, Mundhulens mikroflora, Bakterier...5Decks198Flashcards2Learners -
Mikrobiologi
Mikrobiologi
By: Ragnhild Simonsen
Del 1: mikrobiologi, Del 2: Mattrygghet, Karakterisering, slekter og egenskaper3Decks174Flashcards1Learner -
Mikrobiologi
Mikrobiologi
By: Mariam Hamad
Mikrobiologi1Decks46Flashcards8Learners -
Mikrobiologi
Mikrobiologi
By: Fannie Henriksson
Mikrobiologi - tenta, vårdhygien - tenta, Bakterier och Virus...5Decks460Flashcards1Learner -
Infektion & Mikrobiologi
Infektion & Mikrobiologi
By: user delete
Antibiotika, Bakteriologi, Gott och blandat...5Decks251Flashcards7Learners -
UAB Mikrobiologi
UAB Mikrobiologi
By: GG S
11, 12, 13, 43Decks121Flashcards1Learner -
Mikrobiologi
Mikrobiologi
By: Emilie kolstø
Hva er et annet ord for menneskecelle?1Decks32Flashcards1Learner -
Mikrobiologi och grundläggande Sjukdomslära

Mikrobiologi och grundläggande Sjukdomslära
By: Sara Gudmarsson
Bakteriologi, Tentafrågor, Instuderingsfrågor Bakteriologi...5Decks265Flashcards4Learners



